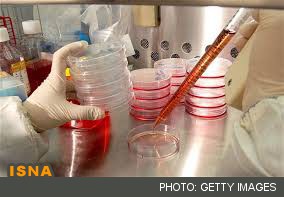
موفقیت محققان در رشد رگ‌های خونی با سلول‌های بنیادی

دانشمندان دانشگاه هاروارد با استفاده از سلولهای بنیادی انسان سلولهای اندوتلیال عروق (نوعی از سلولهای رشته مانند رگهای خونی) تولید کردند که این امر منجر به کشف جزئیات جدید در رابطه با عملکرد این سلولها خواهد بود.
به گزارش سرویس علمی ایسنا منطقه خراسان، این محققان با استفاده از سلولهای بنیادی قلب و نخاع انسان موجب رشد رگهای خونی به روشی جدید شدند. این سلولها با دریافت جریان قوی خون در سلولهای عروقی و جریان خونی ضعیفتری وارد رگها میشوند.
«کیلرمو گارسیا کاردینا»، محقق این تحقیق اظهار کرد: کشف واکنش این سلولها به علائم بیومکانیکی قابل توجه بود.
این تیم تحقیقاتی دریافتند سه عملکرد حیاتی در بدن مانند واکنشهای التهابی، جلوگیری از خونریزی رگها و لخته شدن خون توسط اندوتلیوم در بدن انجام میشود.
این نتایج موجب افزایش ایمنی بیماران نیازمند به دیالیز کلیه یا درمان نقص ریه با کاهش یا حذف نیاز به هپارین ضد انعقاد میشود. عوارض جانبی هپارین رقیق شدن خون است و موجب از دست دادن خون وخونریزی داخلی میشود.
نتایج این تحقیق در نشریه Steam Cell منتشر شده است.
انتهای پیام

نظرات